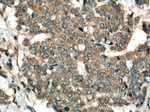
KRT80 Antibody in Immunohistochemistry (Paraffin) (IHC (P))

Search
Proteintech
KRT80 Polyclonal Antibody
{{$productOrderCtrl.translations['antibody.pdp.commerceCard.promotion.promotions']}}
{{$productOrderCtrl.translations['antibody.pdp.commerceCard.promotion.viewpromo']}}
{{$productOrderCtrl.translations['antibody.pdp.commerceCard.promotion.promocode']}}: {{promo.promoCode}} {{promo.promoTitle}} {{promo.promoDescription}}. {{$productOrderCtrl.translations['antibody.pdp.commerceCard.promotion.learnmore']}}
产品信息
16835-1-AP
种属反应
已发表种属
宿主/亚型
分类
类型
抗原
偶联物
形式
浓度
规格
纯化类型
保存液
内含物
保存条件
运输条件
产品详细信息
Immunogen sequence: MACRSCVVG FSSLSSCEVT PVGSPRPGTS GWDSCRAPGP GFSSRSLTGC WSAGTISKVT VNPGLLVPLD VKLDPAVQQL KNQEKEEMKA LNDKFASLIG KVQALEQRNQ LLETRWSFLQ GQDSAIFDLG HLYEEYQGRL QEELRKVSQE RGQLEANLLQ VLEKVEEFRI RYEDEISKRT DMEFTFVQLK KDLDAECLHR TELETKLKSL ESFVELMKTI YEQELKDLAA QVKDVSVTVG MDSRCHIDLS GIVEEVKAQY DAVAARSLEE AEAYSRSQLE EQAARSAEYG SSLQSSRSEI ADLNVRIQKL RSQILSVKSH CLKLEENIKT AEEQGELAFQ DAKTKLAQLE AALQQAKQDM ARQLRKYQEL MNVKLALDIE IATYRKLVEG EEGRMDSPSA TVVSAVQSRC KTAPSLPYPL CSL (1-422 aa encoded by BC065180)
靶标信息
Keratins are intermediate filament proteins responsible for the structural integrity of epithelial cells and are subdivided into epithelial keratins and hair keratins. This gene's expression profile shows that it encodes a type II epithelial keratin, although structurally the encoded protein is more like a type II hair keratin. This protein is involved in cell differentiation, localizing near desmosomal plaques in earlier stages of differentiation but then dispersing throughout the cytoplasm in terminally differentiating cells. The type II keratins are clustered in a region of chromosome 12q13. Two transcript variants encoding two different fully functional isoforms have been found for this gene.
仅用于科研。不用于诊断过程。未经明确授权不得转售。
生物信息学
蛋白别名: CK-80; Cytokeratin-80; K80; keratin 80, type II; keratin b20; Keratin, type II cytoskeletal 80; Keratin-80; type II keratin; type II keratin Kb20; type II keratin-20; Type-II keratin Kb20
基因别名: 1200016G03Rik; 2310041I20Rik; Kb2; KB20; KRT80
UniProt ID: (Human) Q6KB66, (Mouse) Q0VBK2, (Rat) Q6IMF1
Entrez Gene ID: (Human) 144501, (Mouse) 74127, (Rat) 315318